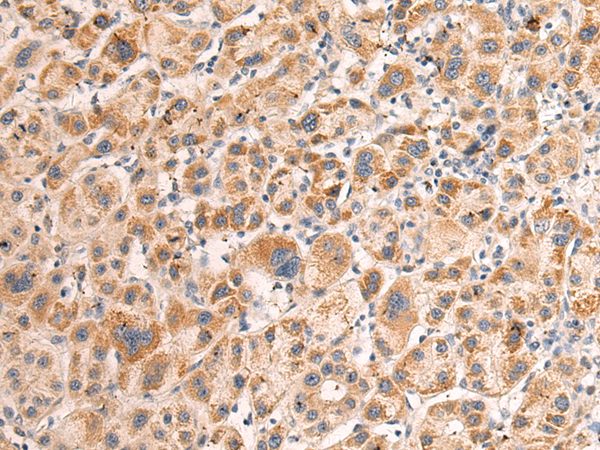
一抗

儲 存: 冷凍(-20℃)
技術(shù)規(guī)格
|
Background: |
Required for DNA double-strand breaks (DSBs) formation in unsynapsed regions during meiotic recombination. Probably acts by forming a complex with MEI4 and REC114, which activates DSBs formation in unsynapsed regions, an essential step to ensure completion of synapsis. Not required for HORMAD1 functions in pairing-independent synaptonemal complex formation, ATR recruitment to unsynapsed axes, meiotic silencing of unsynapsed chromatin (MSUC) or meiotic surveillance. |
|
Applications: |
ELISA, IHC |
|
Name of antibody: |
IHO1 |
|
Immunogen: |
Fusion protein of human IHO1 |
|
Full name: |
interactor of HORMAD1 1 |
|
Synonyms: |
CT74; LELA1; CCDC36 |
|
SwissProt: |
Q8IYA8 |
|
ELISA Recommended dilution: |
5000-10000 |
|
IHC positive control: |
Human liver cancer |
|
IHC Recommend dilution: |
100-300 |

 購物車
購物車 幫助
幫助
 021-54845833/15800441009
021-54845833/15800441009